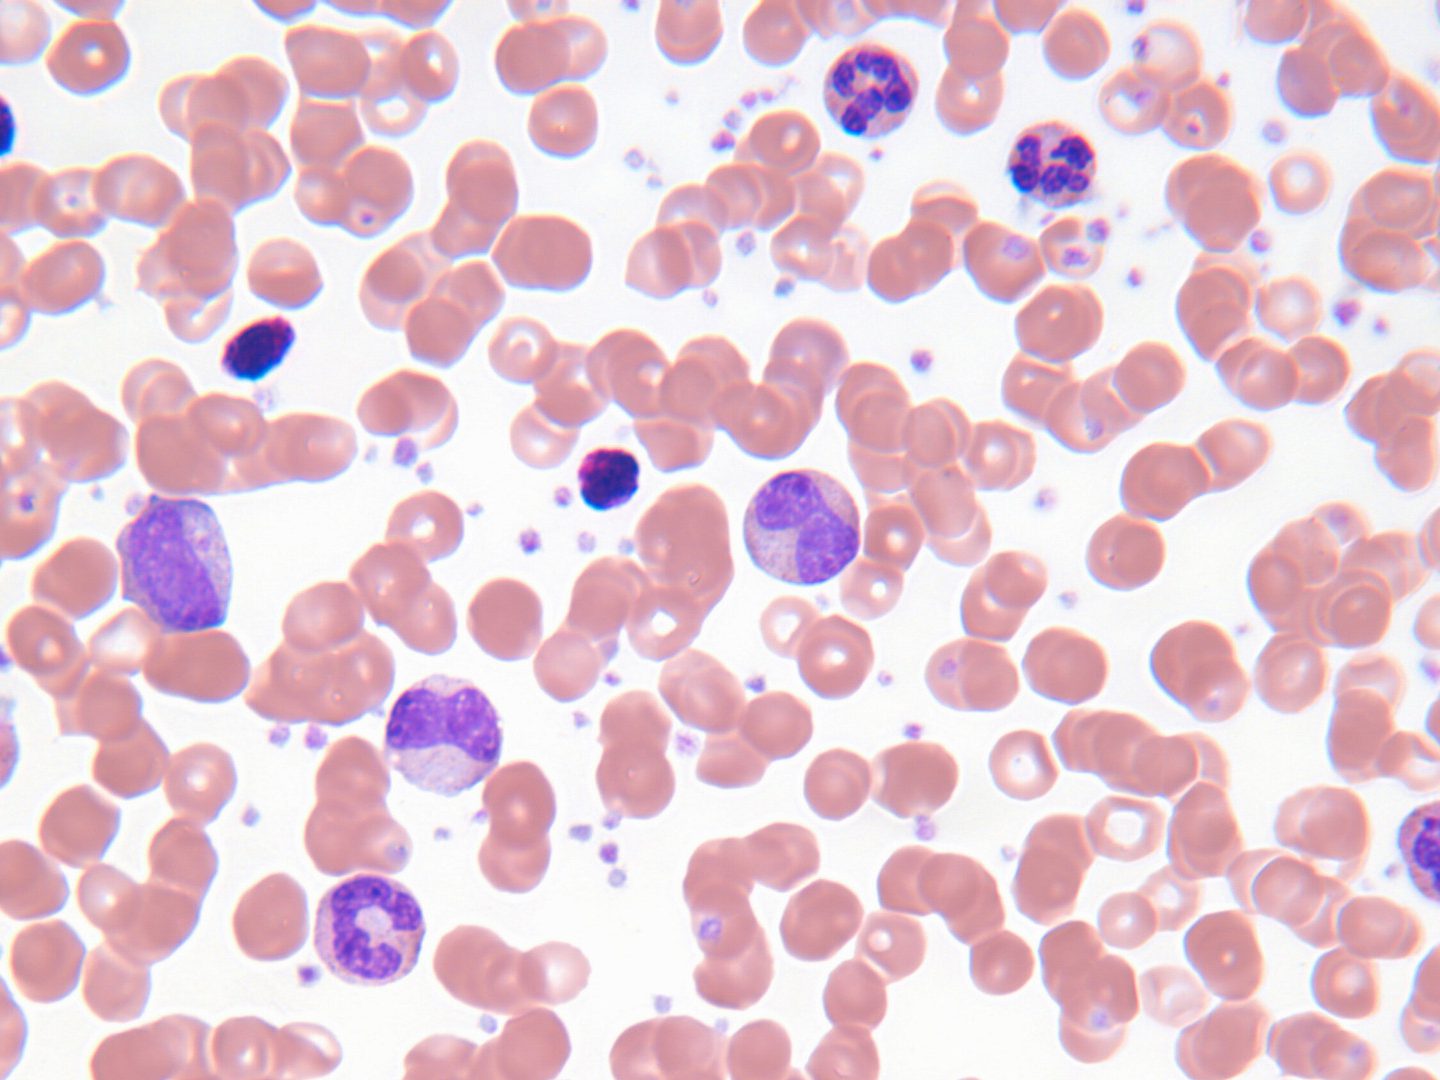
白血病

医療の歴史・がんのインチキ療法
今日のように病原菌を遺伝子レベルで把握し、ワクチンや抗生物質、薬や手術の開発ができるようになるまでに、
それこそ病気になったら神頼みという時代から長い試行錯誤の歴史がありました。

前にご紹介した水銀しかり、ヒ素しかり、今日の常識では考えられないような医療が有効だと信じられていたケースもありました。
先人たちの悪戦苦闘の積み重ねが現代の医療の土台となり、その恩恵を私たちは受けています。
さて、かつて存在していた治療法も、効果の有無はどうであれその殆どは病気や怪我の治癒を目的としたものです。
何当たり前のこと言ってるんだ?
と、思われるかもしれませんが、なんとかして健康になりたいという患者の気持ちを食い物にするインチキ療法もまた、今日と同じように数多く存在していたんですね。
今回は少し寄り道しまして、前回のがん治療に引き続き、
「がんのインチキ治療の歴史」
についてご紹介します。

■がんってどんな病気
ヒトの身体を構成する約60兆個の細胞は通常の場合、細胞数をほぼ一定に保つため分裂・増殖がコントロールされています。
しかし細胞増殖時に遺伝子の異常が起き、正常なコントロールが外れたままどんどん増殖し腫瘍を形成することがあります。
増殖に限度があって、他の組織への移転がない腫瘍を良性腫瘍と言い、逆に歯止めが利かず猛烈に増殖・移転を起こし、私たちを死に至らしめる腫瘍を悪性腫瘍と言います。
後者ががんと言われる状態です。

■獣の臓物療法?
がんを表す Cancerは蟹座Cancerと同じ単語です。
乳癌の腫瘍の広がる模様が蟹の脚のようだったことから、
古代ギリシャの医師ヒポクラテスが「蟹」の意味として古代ギリシア語で「καρκίνος (Carcinos)」と名づけ、後に「Cancer」とラテン語訳されました。
もはやギャグのような話ですが、蟹から名付けられた病気だから蟹を使えば治るのでは?
という考えで、がん治療に蟹が使われたことがあるんです。
ローマ帝国時代の医学者ガレノスは蟹を焼いたあとの破片や灰で軟膏をつくり、それを患部に塗ろうと考えていました。
中世になるとうさぎや子犬、子猫、子羊といった動物を患者に食べさせるという治療法が現れます。

これでも一応理由はあって、がんを患うとがん細胞の激し過ぎる代謝によって栄養がどんどん消費され、
患者の体は痩せていってしまうので、がんは空腹の狼のように体内を蝕む存在だと考えられていました。
そのがんに人間の肉ではなく動物に肉をあげればいいのではと考えられていたんですね。
デタラメのように見えますが、発想が面白いですよね。筋も通っています。
さらに時代が下るとがんの餌としてキツネの肺、トカゲの血、果てはクロコダイルの糞が用いられるようになり、
百歩譲って血や臓物はわかりますが糞って、一体どういう了見なんでしょうね。
肥料になると思ったのでしょうか。
■奇天烈な「ぶどう療法」
1925年、スイスの自然療法医ジョアンナ・ブラントは「ぶどう療法」を発表しました。
赤ブドウだけを食べるという食養生でがんから回復できると彼女は唱えます。

具体的には数日の間断食し、その後2週間にわたってぶどうを一日7食食べるというもの。
同時にぶどう果汁を使ったうがい、膣洗浄、浣腸を行うとなお良いのだそうです。
のちにアメリカがん協会によってぶどう療法は単なる金儲けビジネスだと暴かれました。
■サメの軟骨ががんに効く
現在でも栄養補助食品に使われ、一部の人からがん治療に有効だと信じられている「サメの軟骨」。
サメの軟骨はがんの治療薬として長年研究されてきた歴史があります。
それだけ有望な薬だと期待されていたからだと思いますが、残念ながら明確な有効性は確認されていません。
サメの軟骨は体内で分解される際に、
「がん細胞を死滅させる生成物を放出する」
「免疫細胞の働きを促進する」
「腫瘍が自身の増殖を助けるための血管成長を阻害する」
といった薬効があるとされていました。
「軟骨が骨格の大部分を占めるサメはがんにかからない!」
そうした都市伝説も生まれたくらいです。
まあ、サメもまれにではありますが、がんにかかるようですが。

■猛毒のビタミン薬剤
1970年代に「レートリル」という薬剤が発売されて話題になりました。
ウメ、アンズ、モモ、ビワといったバラ科植物の未成熟な果実や種子に含まれアミグダリンという物質を合成して作ったシアン化合物を原料としています。
シアン化合物は青酸で知られているように、人体にとって猛毒です。

このレートリルはかつてがんに効くとされていました。
健全な細胞には作用せず、がん細胞だけ攻撃するという。
また、アミグダリンが「ビタミンB17」、つまり栄養素として扱われこともあります。
しかし服用者は逆に青酸中毒になり健康障害を引き起こし、場合によっては死に至るといった、およそ健康とはかけ離れた結果となったのです。
現在アメリカでは米国食品医薬品局(FDA)により、アミグダリンの販売は禁止されています。
「癌細胞だけを攻撃する」
「ビタミンの一種であり、アミグダリンの欠乏が癌や生活習慣病の原因となる」
といったアミグダリンが持つとされる健康効果について、その科学的根拠が確認できないにもかかわらず、
この「ビタミンB17」の薬効への信仰は未だ消滅しておらず、インターネットや海外の一部クリニックで販売されています。
■ヒ素、名誉回復か
昔は有害とされていた毒物でも、医療技術の進歩によって薬としても使われ始めたものもあります。
その一つが以前のコラムでご紹介しました「ヒ素」です。

「毒物の王」「王様殺し」「愚者の毒」と呼ばれ、遺産相続を早めるために親族を殺す「相続の粉薬」というなかなか痺れるネーミングもつけられていたほどで、
人間の場合致死量は100mg程度、わずか数時間で死に至らしめることができる猛毒です。
なのにヒ素は梅毒、発熱、胃痛、胸焼け、リウマチ、強壮剤、神経痛、抗マラリア、つわり軽減、若返り、美肌に効く万能薬とされてきました。
近代になって効果がないとわかり、インチキ薬だとして薬の地位を剥奪されたヒ素ですが、21世紀に入って特定の白血病の治療で重宝されるようになります。
三酸化ヒ素による治療が急性前骨髄球性白血病の患者に対する初期の治療法として有効であることが分かり、
がんが進行せず安定した状態の期間を延ばし、さらに生存率を著しく向上させるという。
人に歴史があれば、治療法にも歴史がある。
人への評価が時代によって変わるように、治療法への評価も時代によって変わっていくものなのかもしれませんね。
以上、大禅ビル(福岡市 舞鶴 賃貸オフィス)からでした。
